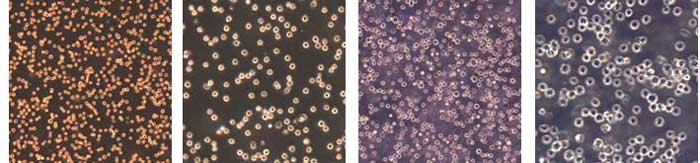

DSZ5000X倒置生物显 微镜用来观察生物切片、生物细胞、细菌以及活体组织培养、流质沉淀等的观察和研究,同时可以观察其他透明或者半透明物体以及粉末、细小颗粒等物体。比较普通生物显 微镜:适合用于观察、记录附着于培养皿底部或悬浮于培养基中的活体物质,在食品检验、水质鉴定、晶体结构分析及化学反应沉淀物分析等领域也能发挥巨大作用。
|
名称 |
技术参数 |
DSZ5000X |
|
光学系统 |
UCIS无限远色差独立校正光学系统 |
● |
|
观察筒 |
双目观察筒,45°倾斜,360°旋转,瞳距52-75mm,±5视度调节 |
● |
|
双目观察筒,45°倾斜,360°旋转,瞳距48-75mm,±5视度调节 |
○ |
|
|
目镜 |
高眼点平场目镜10X/Φ20mm |
●● |
|
高眼点平场目镜10X/Φ22mm |
○○ |
|
|
高眼点平场目镜16X/Φ13mm |
○○ |
|
|
高眼点平场目镜10X/Φ20mm(指针) |
○ |
|
|
高眼点平场目镜10X/Φ22mm(指针) |
○ |
|
|
平场分划目镜10X/Φ20mm |
○ |
|
|
平场分划目镜10X/Φ22mm |
○ |
|
|
对中目镜 |
● |
|
|
物镜 |
无限远长距平场消色差物镜4X |
○ |
|
无限远长距平场消色差物镜10X |
● |
|
|
无限远长距平场消色差物镜20X |
● |
|
|
无限远长距平场消色差物镜40X |
● |
|
|
无限远长距平场消色差物镜60X |
○ |
|
|
无限远长距平场正相衬消色差物镜4X |
○ |
|
|
无限远长距平场正相衬消色差物镜10X |
○ |
|
|
无限远长距平场正相衬消色差物镜20X |
● |
|
|
无限远长距平场正相衬消色差物镜40X |
○ |
|
|
无限远长距平场负相衬消色差物镜4X |
○ |
|
|
无限远长距平场负相衬消色差物镜10X |
○ |
|
|
无限远长距平场负相衬消色差物镜20X |
○ |
|
|
无限远长距平场负相衬消色差物镜40X |
○ |
|
|
载物台 |
固定平台240mmX260mm,移动范围135mmX85mm |
● |
|
多功能载物片座(76X26,Φ54) |
● |
|
|
多孔板座(125X85,96孔) |
○ |
|
|
机械移动载物台350mmX208mm,移动范围50X50mm |
○ |
|
|
水滴载物片(Φ118) |
○ |
|
|
转换器 |
五孔内定位转换器 |
● |
|
相衬装置 |
相衬环板推拉组 |
● |
|
摄像接口 |
C接口 |
● |
|
电源 |
6V30W卤素电源箱 |
● |
|
6V30W进口卤素灯 |
● |
|
|
附件 |
防尘罩 |
● |
上一个产品:生物显微镜 BE202i
下一个产品:奥林巴斯显微镜改造